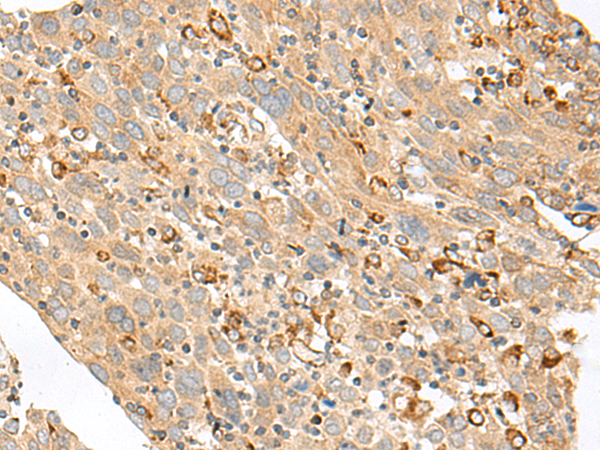

中文名稱(chēng): 兔抗SLC5A1多克隆抗體
英文名稱(chēng): Anti-SLC5A1 rabbit polyclonal antibody
相關(guān)類(lèi)別: 一抗
儲(chǔ) 存: 冷凍(-20℃)
宿 主: Rabbit
抗 原: SLC5A1
反應(yīng)種屬: Human, Mouse, Rat
標(biāo) 記 物: Unconjugate
克隆類(lèi)型: rabbit polyclonal
技術(shù)規(guī)格
|
Background: |
This gene encodes a member of the sodium-dependent glucose transporter (SGLT) family. The encoded integral membrane protein is the primary mediator of dietary glucose and galactose uptake from the intestinal lumen. Mutations in this gene have been associated with glucose-galactose malabsorption. Multiple transcript variants encoding different isoforms have been found for this gene. |
|
Applications: |
ELISA, WB, IHC |
|
Name of antibody: |
SLC5A1 |
|
Immunogen: |
Synthetic peptide of human SLC5A1 |
|
Full name: |
solute carrier family 5 member 1 |
|
Synonyms: |
NAGT; SGLT1; D22S675 |
|
SwissProt: |
P13866 |
|
ELISA Recommended dilution: |
5000-10000 |
|
IHC positive control: |
Human cervical cancer and Human colorectal cancer |
|
IHC Recommend dilution: |
50-300 |
|
WB Predicted band size: |
73 kDa |
|
WB Positive control: |
Mouse eye tissue lysate |
|
WB Recommended dilution: |
500-2000 |

購(gòu)物車(chē)
幫助
021-54845833/15800441009
